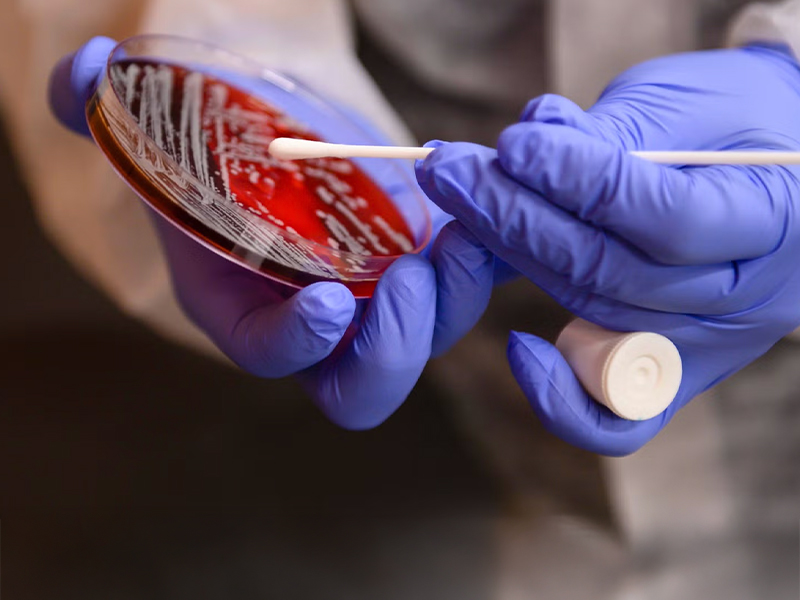
Placeholder

Transform Your Future at Georgia Southern. Whether you see yourself in the classroom, the C-suite or the OR, a degree from Georgia Southern takes you places.
Tackling Georgia’s Biggest Questions
and BEYOND
Georgia Southern research influences the industries that drive our region and protects the natural resources and coastlines so vital to our future. With a focus on manufacturing, innovation, fitness, supply chains and the environment, our faculty put their expertise to work for everybody, every day.
Our Research
Which Georgia companies will innovate global supply chains?
Savannah is home to the nation’s fourth-largest container port. Through our Savannah Logistics Innovation Center (SLIC) and our partnership with Silicon Valley venture capital firm Plug and Play, made-in-Georgia advances find worldwide application.

How can public safety officials perform their best, mentally and physically?
Staying physically fit demands regular exercise, and so does mental fitness. Experts from our Tactical Athlete Readiness and Preparedness Program (TARP) worked closely with state officials to help police cadets focus on all-around wellness and avoid injury.

How are oyster beds and climate change connected?
Our project to restore oyster beds along Savannah waterways preserves a vital ecosystem while keeping carbon out of the atmosphere to help counteract climate change.

How will next-generation materials improve our world?
Researchers at our new Center for Advanced Materials Science are sparking innovation in renewable energy, health care, computing and countless other fields.

How can we inspire more youth to teach?
Our “Teacher for a Day” program, a collaboration with a local elementary school and the organization 100 Black Men of Savannah, introduced underserved students to the doors a college education can open, as well as the opportunities a teaching career makes possible.

Sustainable Fuels
The collaborative efforts of our faculty researchers join with corporate partners are driving innovations in sustainable fuel technologies to find real solutions to the complex problems of sustainable fuel sources and pave the way for a cleaner energy future.
How can we improve community health for a better tomorrow?
At Georgia Southern University, our researchers and community partners are transforming health outcomes through innovative initiatives that integrate research, collaboration, and practice to improve lives locally and globally.
Eagle Stories
As Eagles, we lift each other up to surge past preconceived boundaries. Leaving your comfort zone behind means unlocking a new realm of possibility — internships that become full-time jobs, lifelong friendships and research with a rippling effect across society. See how Eagles soar — and all the places they go.

Barbara Melvin ’92
CEO of the South Carolina Port Authority
I applied to some other schools, but Georgia Southern was the choice I wanted. As soon as I got accepted, that was the end of it. I don’t even think I opened up any other letters.”

Carla Metts, ’14
Emmy Award-Winning Sports Anchor and Host of NASCAR Countdown Live
Some of the best things happen when you least expect it and in the places that you’re not looking. Georgia Southern was that place for me — my teammates, my coaches, my professors who became friends.”
Emmy Award-Winning Sports Anchor and Host of NASCAR Countdown Live

Jaime Weeks, ’21 & ’24
Vice President of Restaurant Services, Innovation and Training at The Wendy’s Company
Say yes even if you don’t feel like you are ready. There were so many times in my career when I was given additional responsibility or opportunities I didn’t necessarily feel prepared for. But nobody is ever ready. Your future — your next great opportunity — may be waiting on the other side of that one that was rooted in recognizing and highlighting diversity.”
Vice President of Restaurant Services, Innovation and Training at The Wendy’s Company
Read Jaime's Story
Georj Lewis, Ed.D., ‘07
Clayton State University President
Being at Georgia Southern was one of the best times in my life and in my career. It was faith, adventure and growth for me and my family, and a lot of happiness.”

Tammie Williams, ’98 & ’15
Senior Vice President and Head of Global Content Finance
Georgia Southern taught me how to be an accountant as a whole person, not just a business professional. The connections I’ve made since then are from doing the right thing by people without wanting anything from them, just treating them right over the years.”
Warner Brothers Discovery Senior Vice President and Head of Global Content Finance, Retired
Read Tammie's StoryOur Commitment to Affordability
The average Georgia Southern undergraduate earns over $78,000 a year after graduation. We help you tap into those opportunities with generous financial aid that makes our already-low tuition even more affordable.
Tuition and ScholarshipsHow Will You Take Flight?
Eagles rise together but often with different destinations in mind — from starting or completing a bachelor’s degree to building their credentials or planning for the next life stage.
Explore Our Locations
At Georgia Southern, you can earn a certificate or degree in the setting that works best for you. Study on one of our three campuses, connect through Army Education Centers, learn online or explore global opportunities at the Wexford Learning Center in Ireland. Wherever you start, your Georgia Southern experience is built to help you move forward.
Campuses & Locations
Your Future Starts Here
You’re eyeing your goal — your dreams and all you’ll accomplish along the way. Georgia Southern not only gives you the platform to reach for it but helps you build momentum to break through and soar beyond.

























